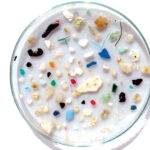

Photo courtesy of Tara ExpeditionsIn late October, the research schooner Tara returned to Lorient, France, after spending two and a half years collecting and studying samples from coral reefs in the Pacific, home to 40 percent of the world’s reefs. In the course of the voyage, Tara went through the Panama Canal to Japan, New Zealand then to China, collecting over 36,000 samples from 32 reefs along the way. Comprised of coral reef biologists, geneticists, oceanographers, reef fish and plankton specialists, bioinformaticians and doctors, the team hopes to eventually pinpoint optimal conditions for reef health and understand the adaptive abilities of the organisms in these ecosystems. This information will, in turn, be used to bolster future rehabilitation and conservation efforts.
It should come as no surprise that the team’s findings also suggest the world’s oceanic ecosystems are very much under attack. Interestingly, damage to the reefs was unevenly distributed and initial observations note that certain sites, like the Chesterfield Islands, were relatively intact while other sites, like the Samoan Islands, sustained heavy damage due to climate change.
The Pacific provided a stunning backdrop for the researchers;
Samples taken from the reefs revealed significant damage in some areas
This uneven damage suggests that both local and global stress factors are to blame for reef destruction. In some ways, this is good news in that, while no single community can reverse the global damage, smaller scale cleanup projects can still have a big impact on local reefs. At press time, the researchers are still analyzing their findings, however, they are already recommending the following six strategies for individuals, marine businesses and lawmakers who want to make a difference:
• Improve waste management, especially for plastic
• Limit the impact of agriculture, livestock breeding and associated effluent
• Prevent deforestation to stabilize soil and thereby prevent runoff sedimentation on the reefs
• Ban or restrict the most destructive fishing practices
• Prioritize the environment when developing heavy coastal infrastructures like dikes and industrial ports
• Involve and educate local populations, leading them to preserve their natural environments.
For more on the Tara voyage and the crew’s findings, visit oceans.taraexpeditions.org/en
January 2019